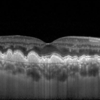

Nouveau cabinet d’ophtalmologie situé dans l'agglomération de Châlons en Champagne et Epernay
Actualités
La prise de rendez vous peut se faire :
- Sur Doctolib ou en cliquant sur "Prendre Rendez-vous".
- Par téléphone : 03 52 82 97 06
- Par formulaire de contact en cliquant sur "Nous contacter"
En cas d’urgence en dehors des horaires d'ouverture et en l'absence de réponse de notre part, le service d’ophtalmologie du CHU de Reims pourra vous accueillir.
NOTRE PLATEAU TECHNIQUE
UNE EQUIPE A VOTRE SERVICE


Parcours et formation :
Chef de clinique des universités
Assistant des hopitaux de Reims
Diplômé de la faculté de Médecine de Reims
Spécialités Médico-chirurgicale :
Rétine Médicale ( DMLA, Diabete, OVCR...)
Glaucome
Myopie de l’enfant
Chirurgie de la rétine
Chirurgie de la Cataracte
Chirurgie Réfractive

Dr PREVOST Ophélie
Ophtalmologue

Dr GROSSELIN Mathilde
Ophtalmologue




Parcours et formation :
Ancienne assistante du CH de Troyes
Ancienne assistante des hopitaux de Reims
Diplômé de la faculté de Médecine de Reims
Spécialités Medico-chirurgicale :
Rétine Médicale ( DMLA, Diabete, OVCR...)
Glaucome
Ophtalmo-Pédiatrie
Chirurgie de la Cataracte
Parcours et formation :
Ancienne assistante du CH de Chalons en Champagne
Ancienne assistante des hopitaux de Reims
Diplômé de la faculté de Médecine de Reims
Spécialités Medico-chirurgicale :
Chirurgie de la Paupière
Glaucome
Ophtalmo-Pédiatrie
Chirurgie de la Cataracte
Informations pratiques
Accéder au cabinet
Cabinet Ophtalmologique Champenois
20 route de louvois
51520
Saint-Martin-sur-le-Pré
10 rue de la cote Legris
51200
EPERNAY
Bus ligne 6 ou 7 arrêt Gare CBR
à 15 minutes de la cathédrale de Châlons en champagne
Informations pratiques
- Le Dr RAMOUL exerce dans le secteur conventionnel à honoraires libres dit SECTEUR 2, adhérent à l’option de pratique tarifaire maîtrisée OPTAM
- Le Tiers Payant AMO est réalisé systématiquement
- Moyens de paiement acceptés : espèces, chèque, carte bancaire
- Carte vitale acceptée
Pensez bien à apporter vos lunettes, ordonnances et examens médicaux.
N'oubliez pas de retirer vos lentilles 24 heures avant la consultation